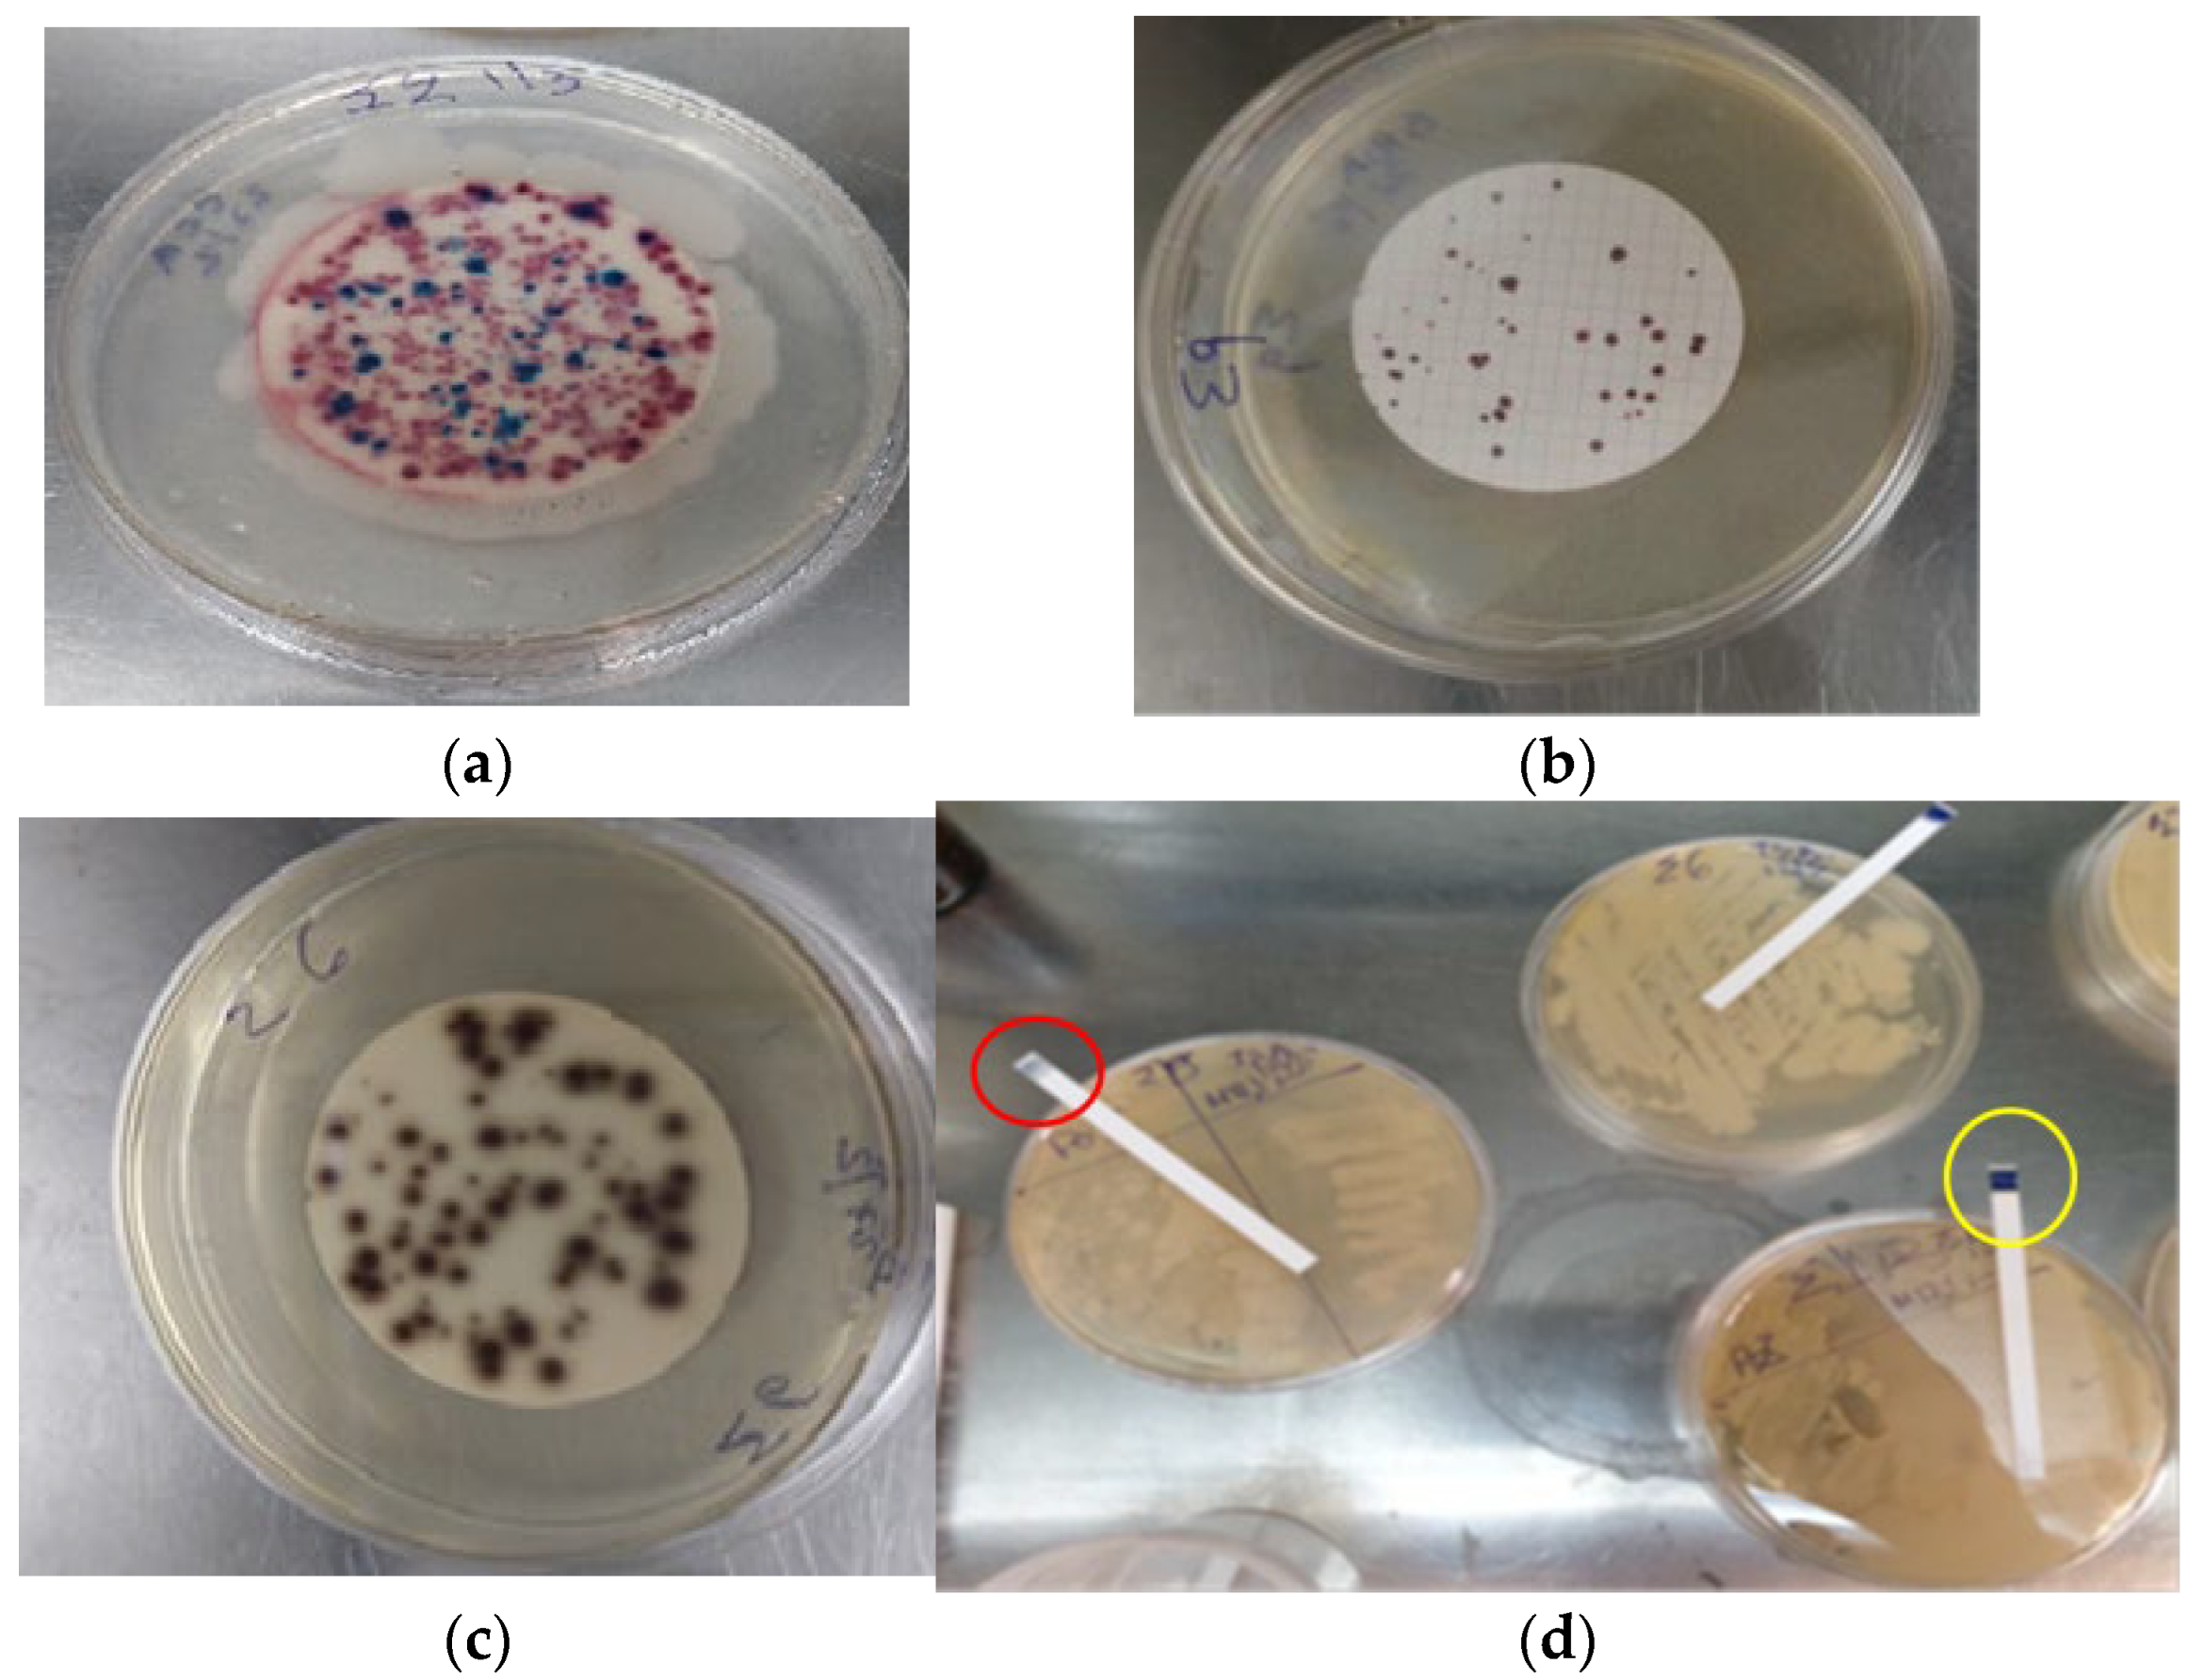
Preprints 117391 g001

1. Introduction
The contamination of ecosystems has either direct or indirect impact on human health [
1]. Poor treatment of waste and its discharge into the sea leads to the contamination of coastal recreational areas with microorganisms. Almost all epidemiological studies conclude that there is a significant risk to the health of people swimming in coastal areas where estuaries are found [
2,
3,
4,
5,
6,
7,
8]. The increase of human activities for the purpose of either tourism or recreational activities is evidenced by the fact that two-thirds of the world’s population resides in coastal areas, and this number tends to increase even more [
9,
10]. A number of years ago, the quality of bathing waters were a matter of concern for the EU, which had to be safeguarded in the interests of public health and tourism. In this respect, the EU adopted Directive 2000/60/EC [Water Framework Directive (WFD)], which is a landmark. The geomorphology of the soil and the high tourist presence on the beach are factors contributing to the increase of the number of FIBs [
7,
11,
12,
13,
14,
15,
16]. The total number of bacteria present in sewerage is estimated to be 106/ml to 107/ml, of which approximately 105/ml or, according to others, 106/ml to 108/100 ml belong to the E. coli group and constitute 1% of the biomass in the large intestine [
17,
18]. An average of 1,95x109 coliforms are produced from human feces per day [
19]. The bacterium Escherichia coli – irrespective of whether it originates from animal or human feces – is the best biological indicator of fecal contamination of the water [
20], indicating the possible contamination of the water with other pathogenic microorganisms. It can be easily and rapidly counted in recreational waters, as several studies have shown that its presence is associated with the incidence of gastrointestinal disorders in swimmers [
21,
22,
23,
24,
25,
26,
27,
28]. The prevalence of diarrheal diseases caused by E. coli strains in coastal recreational areas is increasing due to the increased presence of human waste [
29,
30]. The same results were also confirmed by a more recent (2016) study on diarrhea symptoms in children [
31]. Fecal enterococci are part of the normal flora of humans and warm-blooded animals, are always present in feces [
32], resistant to environmental conditions, and their possible presence in water combined with the absence of the bacterium E. coli indicates an old fecal contamination of the water. Enterococci are the best bacterial indicator for assessing fecal contamination of marine waters as well as their association with waterborne diseases [
11,
33,
34,
35]. The major source of fecal bacteria on a beach are humans [
36,
37,
38] and animals. Increased phosphorus concentrations in agricultural waste lead to an increased presence and abundance of both fungal and bacterial pathogens [
39,
40,
41,
42]. The main threats to health associated with waterborne pathogenic bacteria are attributable to human feces as well as to domestic waste waters, industrial and hospital sewage, and urban or rural runoff [
40,
43,
44,
45]. It is noteworthy that increased concentrations of enterococci and total coliforms are observed following rainfall and storms [
32,
46,
47,
48]. Total coliforms can proliferate in nature even in the absence of sewage, when the E. coli group, fecal coliforms and enterococci are in warm environments. In addition to the intestinal flora of humans and warm-blooded animals, however, coliforms can also be found in many species of cold-blooded animals [
49,
50,
51], and they constitute a useful tool for assessing recreational waters quality in case they are contaminated with waste water. In recent years the effort of scientists has been focused on trying to predict contamination in similar areas with innovative and intelligent methods [
52].
2. Materials and Methods
The method used for the isolation of bacteria was the membrane filtration method described in ISO 7704:1985 [
53]. For the growth and enumeration of total coliforms and Escherichia coli the method described in ISO 9308-1/2014 [
54] was used, while for enterococcus the one described in ISO 7899-2:2001 [
55].
2.1. Samling, Agar and Chemicals
The sampling was conducted in the morning hours and the water samples were transported to the laboratory in an isothermal container in order to preserve the microbial population under the best possible conditions and minimize the effect of external factors, such as heat. The analysis of the samples was performed within 8 hours. The sample volume was 500 ml. The sampling frequency was during the four seasons of the year. The nutrients used are, as follows:
The agar Harlequin® Chromogenic Agar of the manufacturer Neogenusa (CCA referred to in ISO 9308-1) was used for the enumeration of Escherichia coli and coliforms. CCA was made by dissolving 28.7 grams in 1 liter of water.
The substrate m–Enterococcus agar (Slanetz-Bartley Medium (referred to in ISO 7899-2:2001) of the same manufacturer was used for enterococcus. Slanetz-Bartley Medium was made by dissolving 43.5 grams in 1 liter of water.
The method involves the filtration of a sample of 100 ml through a membrane filter; the membrane filter is subsequently placed on a CCA to allow the growth of coliforms and E. coli, and on an Slanetz-Bartley Medium to allow the growth of enterococci. The incubation was performed at a temperature of 37°C for 24 ±2 hours. The confirmatory methods which were used for the enumeration of E. coli and coliforms following the use of Harlequin® Chromogenic Agar are, as follows: First confirmation test using Tryptone Soy Agar (TSA). About 10 red/pink colonies were picked from the CCA plate and then each sample was plated on TSA. Finally, an incubation was performed at 35-37°C for 24 ±2 hours. Second confirmation test using oxidase strips. Test performed on TSA colonies using oxidase strips. Samples are oxidase positive when the color on the strip is changed to blue – light purple. The medium Bile Esculin Agar was used for the detection and enumeration of enterococci. The procedure followed for all samples is, as follows: a membrane was placed on a Slanetz-Bartley Medium plate and then transferred to the Bile esculin agar medium plate. Subsequently, the plate was incubated in inverted position at 44±0.5 °C for 2 hours. Furthermore, according to ISO 9308-1: “total coliforms bacteria are the sum of oxidase negative colonies with pink to red color and all dark-blue violet colonies”. The laboratory research was carried out in the Pineios Delta area, very close to the city of Larisa, in the geographical region of Thessaly, and involved the coastal areas of this region. Samplings were conducted throughout the year.
3. Results
It should be noted that the samples collected in November 2023 and February 2024 are of particular importance as they allow us to draw useful data for the study areas following the Storm Daniel, which affected the wider area of Thessaly, Greece, an area which is crossed by Pineios River and into which its tributaries empty. Thus, conclusions for the water contamination prior and following the said storm can be drawn.
3.1. Study Area
Pineios Delta (Figure 1, Supplementary Figure) occupies an area of approximately 8.585 m
2 (2.121 acres) and is located in the Municipality of Tempi of the Regional Unit of Larisa of the Region of Thessaly. It is an extensive deltaic system sourced from the largest river in Thessaly. The total length of Pineios River along with its dispersions and meanderings is approximately 262 km. The climate of the area in question is Mediterranean on the eastern side and continental on the central and western sides, with two landscape variations – mountainous and lowland landscape – depending on the geological conformation. The temperature differences in the area between the seasons are large due to the fact that winters are cold while summers particularly hot. The coldest months are January, February, and December, while the warmest are July and August [
56]. Pineios River is the recipient of the greatest amount of pollutants in the area. The major sources of pollution include treated urban and industrial waste and the intense agricultural and livestock activity that takes place in the Thessalian plain [
57]. The delta area is of great ecological and socio-economic significance due to its rich biodiversity and natural beauty. The Pineios Delta area has been registered in the CORINE Biotopes database (1988) and designated as a Special Protection Area for the conservation of wild birds in accordance with Directive 79/409/EEC. Moreover, it belongs to the Natura 2000 network (code number GR1420002) and has wetlands, habitats, wild olive and olive groves, pastures, coastal and riverside forests, sand dunes, and sandy moors [
58].
Cullera Bay is a coastline of approximately 6 km on the Mediterranean coast. Jucar River (with a length of 509 km), which carries sewage and waste from the urban and industrial areas it crosses, flows therein. Cullera Bay is delimited to the north by the cape of the same name and to the south by open sea. The city of Cullera is situated 38 km south of the city of Valencia. The study covers a period from July 2002 to April 2003. As mentioned in the literature, the samples were collected from 11 sites on the Cullera coastline. The bacteria which were studied are Enterococcus and Escherichia coli. There is a high influx of tourists in the area during summer months (21,500 residents during winter while this figure is 150,000 during summer [
59], while the direction of the winds also affects the pollution of the area [
60,
61]. Furthermore, in Cape Cullera a notable increase of bacteria considered that driven by seasonal winds. Three sampling campaigns were conducted between July 2002 and April 2003 at 11 sites described in the search article. As concerned, E.Coli the values were far above the maximum limits on site 1 (1600 cfu/100ml) in July were the bay is more enclosed. On the said site enterococcus values were exceeded the permitted limits according to the same samples (166 cfu/100ml). The results of the September 2002 samples showed that E.Coli values were exceeded the permitted limits on site 2(991 cfu/100ml). An outbreak of E. Coli was observed in April 2023 on site 3(2021 cfu/100ml) the highest values that mentioned. Enterococcus values were within the permitted limits on all sites according to this sample. The results on the southern site, where the sea is open, showed that E.Coli and Enterococcus values were in the permitted limits.
Gonzaguinha and Ilha beaches, Brazil. The results revealed that at Gonzaguinha beach E. coli values were far above the maximum limits with 2640 cfu/100ml. At Ilha beach the maximum limits were not exceeded.
Miami Beach – Florida, USA. Enterococci concentrations were particularly high during the wet season. At area level, the concentrations of microorganisms showed differences regarding the distance from the coast. The concentrations were high in coastal areas and low in offshore areas. At Grandon Beach the number of enterococci was 95% less than that at Hobie Beach. The two count sites at Hobie Beach (sites H1 and H2) showed differences in the concentrations of all microbes, with site H2 having a 95% higher concentration than site H1. The study revealed increased concentrations of enterococci on the shore during a tide, with the maximum value reaching 306 cfu/100 ml on the west and east sides of the beach.
3.2. Legislation
The legislative frameworks on the parameters in the study areas are summarized in Tables 1,2, where the bathing water quality classification is shown. Microbiological status of the waters in accordance with Framework Directive 2006/7/EC. Table 2 shows the limits (desirable and maximum) for bathing waters. The evaluation of all data will be carried out in accordance with the current European legislation. The samples were collected during the months of May, August, November 2023, and February 2024. Table 3 (supplementary material) presents the results of the microbiological analyses in detail.
The number of colony forming units is expressed in cfu/100 ml. Some of the analysis results are given in
Figure 1.
The study results of May 2023 samples showed that Total Coliforms values were within the desirable limits on all coastal sites in Τhessaly, Greece. Regarding the E. coli bacterium, the results demonstrated that its values were above the desirable limits only in Nea Messagala (280 cfu/100ml) in the samples of the same month and in Spain exceeded the legal limits (Figure 3, Supplementary Figures). Enterococcus values were also above the maximum limit in Nea Messagala (600 cfu/100ml) and USA (Figure 4, Supplementary Figures). As far as August 2023 samples are concerned, the results showed that E. coli values exceeded the desirable limits in Agia Paraskevi (369 cfu/100ml), Nea Messagala (373 cfu/100ml), and in Spain and Brazil exceeded the legal limits (Figure 5, Supplementary Figures). Enterococcus values were within the permitted limits on all these sites in the aforementioned samples. As for November 2023 samples, the results revealed that Total Coliforms values exceeded the desirable limits in Alexandrini (519 cfu/100ml), Stomio – Faros area (621 cfu/100ml), Nea Messagala (528 cfu/100ml) (Figure 6, supplementary Figures). E. coli values were also above the desirable llimits in Nea Messagala (360 cfu/100ml) according to the samples of the same month and in Spain exceeded the legal limits (Figure 7, Supplementary Figures). Enterococcus values were within the permitted limits on all sites in the samples in question. The results of February 2024 samples showed that Total Coliforms values exceeded the desirable limit in Alexandrini (1446 cfu/100ml), Stomio – Faros area (1410 cfu/100ml), and Nea Messagala (1347 cfu/100ml) (Figure 8, Supplementary Figures). E. coli values were above the desirable limits in Alexandrini (432 cfu/100ml) according to the same samples (Figure 9, Supplementary Figures). Enterococcus values exceeded the maximum legal limits in Alexandrini (399 cfu/100ml), Stomio – Faros area (225 cfu/100ml), and Nea Messagala (426 cfu/100ml) (Figure 10, Supplementary Figures). Following the completion of the microbiological analyses during all seasons of the year, the times series for all microbiological parameters for the period from May 2023 to February 2024 were generated (Figure 11 to 14, Supplementary Figures). In Alexandrini an increase in Total coliforms and E. coli is observed following the extreme floods in Thessaly, Greece, at the end of 2023; this is due to the fact that Pineios River empties into this area. In Agia Paraskevi an outbreak of Total Coliforms (657 cfu/100 ml) and E. coli is observed during August 2023 and February 2024 (Total Coliform count: 384 cfu/100 ml) (Figure 12, Supplementary Figures). The increase in those values during August is due to the fact that it is summer vacation period and, therefore, the influx of tourists is higher. Furthermore, this is due to the geomorphology of the area and the fact that the bay is enclosed. In Stomio – Faros area an increase in Total Coliforms and E. coli is observed during summer months due to the high influx of bathers. This Total Coliforms increase was even more pronounced following the flood events occurred in the Region of Thessaly in Greece in the autumn of 2023. Moreover, enterococcus values exceeded the permitted limits in February 2024. In Nea Messagala an outbreak (i.e. values three times higher than the maximum limits) of enterococcus was observed in May 2023. E. coli values exceed legal limits during summer (and 373 cfu/100 ml). A rapid increase of Total coliforms was observed following the floods of 2023, with their value being 1347 cfu/100 ml in February 2024.
3.3. Statistical Analysis
SPSS package was used and Mann – Whitney Test was performed. No statistically significant difference was found before and after the flood events, for any of the two (E. coli P=0,263>0,05 and Enterococcus P=0,938>0,05) pathogenic bacteria (Table 4 – Supplementary material). No statistically significant difference was found at all points in Greece (except Agia Paraskevi – Stomio) and Spain, for either of the two pathogenic bacteria (Table 5). All P values ranged from 0,065 till 0,221.
4. Discussion
In this work, the microbiological contamination of river deltas was achieved in similar areas (Greece and Spain, Table 5 Supplementary material) and could be applicable throughout the Mediterranean. Therefore, the present study can be applied to areas with similar characteristics throughout the Mediterranean. The limitations of the research are that it can be applied to areas with the same geomorphology, climate temperature, winds and whether they are tourist resorts. The detailed analysis of the study areas shows that the areas of Florida, Miami, Hobie beach, USA, and Gonzaguinha beach in Brazil are enclosed bays with poor water circulation. Furthermore, the climate in Florida, Miami, Grandon beach in the USA, and Ilha beach in Brazil is tropical and subtropical, and the said areas are located in open ocean waters. Thus, these four areas cannot be compared to the other study areas. The only areas that can be compared to each other are the Pineios Delta areas and the Jucar River areas in Spain. The above areas have common natural, geomorphological and climate characteristics. In addition, both areas are near city centres – Larissa and Valencia, respectively –, and both areas are a magnet of tourists during summer months, and, thus, recipients of treated wastewater and urban and industrial waste. Prior to comparing the microbiological analysis results, we should take into account that the length of Pineios River is half the length of Jucar River, on the one hand, and that a flooding occurred in Greece in September 2023, resulting in higher coliform values in those areas, on the other hand. No statistically significant difference was found before and after the flood events in Greece, for E. coli and Enterococcus bacteria (Table 4, Supplementary material). The microbiological analysis results indicate that in summer 2023 Escherichia Coli value reached 373 cfu/100ml in Greece and 1600 cfu/100ml in Jucar River (Figure 5). The analysis results for autumn (October) of the same year in Greece (360 cfu/100ml in Sbuka Beach Bar in Nea Messagala) and Spain (991 cfu/100ml) are proportionate to each other. Moreover, the water pollution with the Escherichia Coli bacteria remained at the same levels as that of summer months caused by the influx of tourists in Greece due to the floodings occurred in October 2023. In contrast, the pollution of the Jucar River waters reduced in October 2023, as no tourist activities have taken place, which could lead to water pollution. No statistically significant difference was found at all points in Greece (except Agia Paraskevi – Stomio) and Spain, for E. coli and Enterococcus pathogenic bacteria (Table 5). It is noteworthy that the number of Total coliforms in February 2024 in Greece reached the same levels as E. coli in Spain. Additionally, the only checkpoint in Greece that meets the requirements of Directive 2006/7/EC is Agia Paraskevi. A future research improvement could be the modeling the two rivers flow in Greece and Spain.
5. Conclusions
A key achievement of the research is that the contamination correlation of river deltas was achieved in similar areas (Greece and Spain). Continuous monitoring of contamination in sensitive delta areas throughout the Mediterranean Sea is a key issue for the protection of society, public health and environment.
Supplementary Materials
The following supporting information can be downloaded at the website of this paper posted on Preprints.org.
Author Contributions
For research articles with several authors, a short paragraph specifying their individual contributions must be provided. The following statements should be used “Conceptualization, K.K.; Methodology, L.M.; software, K.K.; validation, K.K.; formal analysis, K.K.; investigation, K.K.; resources, K.K.; data curation, B.D.; writing—original draft preparation, K.K. and L.M.; writing—review and editing, K.K. and L.M.; visualization, K.K.; supervision, K.K.; project administration, K.K.; All authors have read and agreed to the published version of the manuscript.”.
Funding
This study received no external funding.
Data Availability Statement
Data presented in this study are available on request from the corresponding author.
Acknowledgments
The authors would like to thank Mr. Kalousis Athanasios for his valuable help in collecting the samples and Birbilis Dimitrios for data curation.
Conflicts of Interest
The authors declare no conflict of interest. The funders had no role in the design of the study, in the collection, analyses, or interpretation of data, in the writing of the manuscript, or in the decision to publish the results.
References
- European Environment Agency (2018) Sources of water pollution Available from: https://www.eea.europa.eu/themes/water-pollution. [Last accessed on, 21-6-2018].
- Turner, J.W., Elledge, N.C., Wallgren, H.R., Amend, S.M., 2019. A bacterial source tracking project to identify sources of fecal pollution in Little Bay: May 2018–January 2019. Coastal Bend Bays and Estuaries Program, Publication 127, Project 1816. Available from: https://www.cbbep.org/publications/publications.html.
- Donovan, E., Unice, K., Roberts, J.D., Harris, M., Finley, B. Risk of Gastrointestinal Disease Associated with Exposure to Pathogens in the Water of the Lower Passaic River. Appl. Environ. Microbiol. 2008, 74, 994–1003. [CrossRef]
- Yau V, Wade TJ, de Wilde CK, Colford JM Jr. Skin-related symptoms following exposure to recreational water: a systematic review and meta-analysis. Water Qual. Expo Health 2009, 1:79–103. [CrossRef]
- Rodríguez-Tapia L., Jorge A. Morales-Novelo. Bacterial Pollution in River Waters and Gastrointestinal Diseases. Int J Environ Res. Public Health. 2017, 4,14(5):479. [CrossRef]
- L.A. Cupul-Magaña, C. Mösso-Aranda, A. Sánchez-Arcilla, J.P. Sierra-Pedrico, J.L. Fermán-Almada, I. Romero, S. Falco. Bacteriological quality of the seawater in Cullera Bay, Spain. Ciencias Marinas 2006, 32 (2): 311–318. [CrossRef]
- Elmir, S. Septic Systems Vulnerable to Sea Level Rise. Miami-Dade County Water and Sewage Department, Florida Department of Health, Miami, FL, USA. 2018. Available from: https://www.miamidade.gov/green/library/vulnerability-septic-systems-sea-level-rise.
- Klubi E, Abril JM, Nyarko E, Delagado A. Impact of gold-mining activity on trace elements enrichment in the West African estuaries: The case of Pra and Ankobra rivers with the Volta Estuary (Ghana) as the reference. J. Geochemical Exploration 2018, 190:229-244. [CrossRef]
- Inal A, Boulahdid M, Angelleti B, Radakovitch O. Levels and ecological risk assessment of heavy metals in surface sediments of fishing grounds along Algerian coast. Mar. Pollut. Bull. 2018, 136:322–333. [CrossRef]
- Ouali N, Belabed BE, Chenchouni H. Modelling environment contamination with heavy metals in flathead grey mullet Mugil cephalus and upper sediments from north African coasts of the Mediterranean Sea. Sci. Total Environ. 2018, 639:156–174. [CrossRef]
- Dakka HA, Aljaroucha AE, Allam NG, Shaltout KH. Epidemiological and etiological agents of water borne infections among the bathers in the Mediterranean Sea water in Gaza Strip. Egyp J. Experim. Biol. (Botany) 2018, 14:299-306. [CrossRef]
- Nevers, M.B., Przybyla-Kelly, K., Spoljaric, A., Shively, D., Whitman, R.L., et.al. Freshwater wrack along Great Lakes coasts harbors Escherichia coli: potential for bacterial transfer between watershed environ- ments. J. Great Lake. Res. 2016, 42, 760-767. [CrossRef]
- Whitman, R.L., Harwood, V.J., Edge, T.A., Nevers, M.B., Byappanahalli, M., et.al. Microbes in beach sands: integrating environment, ecology and public health. Rev. Environ. Sci. Biotechnol. 2014, 13, 329. [CrossRef]
- Verhougstraete, M., Rose, J.B. Microbial investigations of water, sediment, and algal mats in the mixed use watershed of Saginaw Bay. Michigan J. Great Lakes Res. 2014, 40 (S1), 75-82. [CrossRef]
- Russell, T., Sassoubre, L., Zhou, C., French-Owen, D., Hassaballah, A., et.al. Impacts of beach wrack removal via grooming on surf zone water quality. En- viron. Sci. Technol. 2014, 48, 2203-2211. [CrossRef]
- Grube, A. M., Stewart, J. R. & Ochoa-Herrera, V. The challenge of achieving safely managed drinking water supply on San Cristobal Island, Galápagos. Int. J. Hyg. Environ. Health 2020, 228, 113547. [CrossRef]
- Edberg, S.C., Rice, E.W., Karlin, R.J. and Allen, M.J. Escherichia coli: The best biological drinking water indicator for public health protection. Symp. Ser. Soc. Appl. Microbiol. 2000, 29: 106S-116S. [CrossRef]
- Leclerc H., Mossel, D.A., Edberg, S.C. and Struijk, C.B. Advances in the bacteriology of the coliform group: Their suitability as markers of microbial water safety. Annu. Rev. Microbiol. 2001, 55: 201-234. [CrossRef]
- Geldreich, E.E. Type distribution of coliform bacteria in feces of warm-blooded animals. J. Water Pollution Control Federation 1962, 34, 295-301.
- Guidelines for Canadian Recreational Water Quality: Indicators of Fecal Contamination Health Canada 2022.
- Arnold BF, Schiff KC, Ercumen A et al. Acute illness among surfers after exposure to seawater in dry- and wet-weather conditions. Am J Epidemiol 2017, 186:866–75. [CrossRef]
- Wu B., Wang C., Zhang Ch., Sadowsky J.M., Dzakpasu M., et al. Source-Associated Gastroenteritis Risk from Swimming Exposure to Aging Fecal Pathogens. Environ. Sci. Technol. 2020, 54:2, 921–929. [CrossRef]
- Napier D. M., Poole C., Stewart R.J., Weber J.D., Glassmeyer T. S., et al. Exposure to Human-Associated Chemical Markers of Fecal Contamination and Self-Reported Illness among Swimmers at Recreational Beaches. Environ. Sci. Technol. 2018, 52:13, 7513–7523. [CrossRef]
- Frick, C., Vierheilig, J., Nadiotis-Tsaka, T., Ixenmaier, S., Linke, et al. Elucidating fecal pollution patterns in alluvial water resources by linking standard fecal indicator bacteria to river connectivity and genetic microbial source tracking. Water Research 2020, 184, 116132. [CrossRef]
- Sanchez, M.H., Bolívar-Anillo, H.J., Soto-Varela, Z.E., Aranguren, Y., Gonzalez, C.P., et al. Microbiological water quality and sources of contamination along the coast of the Department of Atlantico (Caribbean Sea of Colombia). Preliminary results. Mar. Pollut. Bull. 2019, 142, 303–308. [CrossRef]
- Wade, T.J., Pai, N., Eisenberg, J.N. and Colford, J.M.,Jr. Do U.S. environmental protection agency water quality guidelines for recreational waters prevent gastrointestinal illness? A systematic review and meta-analysis. Environ. Health Perspect. 2003, 111(8): 1102-1109. [CrossRef]
- Brooks, Y. M., C. M. Spirito, J. S. Bae, A. Hong, E. M. Mosier, D. J. Sausele, C. P. Fernandez-Baca, J. L. Epstein, D. J. Shapley, and L. B. Goodman. “Fecal indicator bacteria, fecal source tracking markers, and pathogens detected in two Hudson River tributaries. Water Res. 2020, 171: 115342. [CrossRef]
- Besharatipour N., Nikaeen M., Bina B., Gholipour S, Akbar Hassanzadeh A. Microbial Quality of Coastal Areas of Bandar Abbas City: Is there any Potential Risks for Swimmers? Int. J. Env. Health Engineering 2020, 9, pp. 1–5. [CrossRef]
- Holcomb A. D., Stewart R. J., 2020 Microbial Indicators of Fecal Pollution: Recent Progress and Challenges in Assessing Water Quality. Current Environmental Health Reports 2020, 7:311–324. [CrossRef]
- Kelly A. E., Zhixuan F., Gidley L. M., Sinigallian D. C., Kumar N., et.al. Effect of beach management policies on recreational water quality, J Env. Management 2018, 212, pp. 266–277. [CrossRef]
- Arnold BF, Wade TJ, Benjamin-Chung J et al. Acute gastroenteritis and recreational water: highest burden among young US children. Am J Public Health 2016, 106:1690–97. [CrossRef]
- Tomenchok L., Abdool-Ghany A., Elmir M. S., Gidley L. M., Christopher D. Sinigalliano D. C., et al. Trends in regional enterococci levels at marine beaches and correlations with environmental, global oceanic changes, community populations, and wastewater infrastructure. Science Total Env. 2021, 793:148641. [CrossRef]
- Buer, A.L., Gyraite, G., Wegener, P., Lange, X., Katarzyte, M., et al. Long term development of bathing water quality at the German Baltic coast: spatial patterns, problems and model simulations. Mar. Pollut. Bull. 2018, 135, 1055–1066. [CrossRef]
- Jennings, W.C., Chern, E.C., O’Donohue, D., Kellogg, M.G., Boehm, A.B.. Frequent detection of a human fecal indicator in the urban ocean: environmental drivers and covariation with enterococci. Environ Sci Process Impacts 2018, 20 (3), 421–574. [CrossRef]
- Rajapaksha, P.; Elbourne, A.; Gangadoo, S.; Brown, R.; Cozzolino, D.; Chapman, J. A review of methods for the detection of pathogenic microorganisms. Analyst 2019, 144, 396–411. [CrossRef]
- Florini S., Shahsavari E., Ngo T., Aburto-Medina A., David J. et al. Factors Influencing the Concentration of Fecal Coliforms in Oysters in the River Blackwater Estuary, UK. Water 2020, 12(4), 1086. [CrossRef]
- González-Fernándeza A., Symonds M.E., Gallard-Gongora F.J., Mullc B, Lukasikc O. J., et al. (2023). Risk of Gastroenteritis from Swimming at a Wastewater-Impacted Tropical Beach Varies across Localized Scales. Env. Microbiology 2023, 89(3). [CrossRef]
- Gerba CP, Betancourt WQ, Kitajima M, Rock CM. Reducing uncertainty in estimating virus reduction by advanced water treatment processes. Water Res. 2018, 133: 282–8. [CrossRef]
- Paruch L., Adam M. Paruch M. A., Hans Geir Eiken G.H., Roald Sørheim R. Faecal pollution affects abundance and diversity of aquatic microbial community in anthropo-zoogenically influenced lotic ecosystems. Scientific Reports 2019, 9: 19469. [CrossRef]
- Wu D, Su Y, Xi H, Chen X, Xie B. Urban and agriculturally influenced water contribute differently to the spread of antibiotic resistance genes in a mega – city river network. Water Res. 2019, 158:11–21. [CrossRef]
- Papaioannou A., Kakavas K.V., Dovriki Ε., Plageras P, Noulas A. Quality control of groundwater in the region of Thessaly (Greece). Fresenius Environ. Bull., 2006, 15(9 A), 1015–1022.
- Papaioannou, A., Rigas, N., Rigas, G., Athanasios G. Paliatsos, Kakavas, K.V. Multivariate statistical interpretation of soil quality data in the context of public health. Fresenius Environ. Bull., 2009, 18(2), 204–212.
- Cui Q, Huang Y, Wang H, Fang T. Diversity and abundance of bacterial pathogens in urban rivers impacted by domestic sewage. Environ Pollut. 2019, 249:24–35. [CrossRef]
- Al Salah DMM, Ngweme GN, Laffite A, Otamonga J-P, Mulaji C, Pot_e J. Hospital wastewaters: A reservoir and source of clinically relevant bacteria and antibiotic resistant genes dissemination in urban river under tropical conditions. Ecotoxicol Env. Safety 2020, 200:110767. [CrossRef]
- Zhang L, Zhou Y, Cheng Y, Lu W, Liang Y. Effect of different types of industrial wastewater on the bacterial community of urban rivers. J. Freshwater Ecol. 2021, 36(1):31–48. [CrossRef]
- Martinez G, Pachepsky YA, Whelan G, Yakirevich AM, Guper A, Gish T. Rainfall-induced fecal indicator organisms transport from manured fields: Model sensitivity analysis. Env. Int. 2014, 63:121–129. [CrossRef]
- Powers, N.C., Wallgren, H.R., Marbach, S., Turner, J.W. Relationship between rainfall, fecal pollution, antimicrobial resistance, and microbial diversity in an urbanized subtropical bay. Appl. Environ. Microbiol. 2020, 86(19). [CrossRef]
- Yu P, Zaleski A, Li Q, He Y, Mapili K, et al. Elevated levels of pathogenic indicator bacteria and antibiotic resistance genes after Hurricane Harvey’s flooding in Houston. Env. Sci. Technol. Lett. 2018, 5:481–6. [CrossRef]
- Tenaillon, O., Skurnik, D., Picard, B. and Denamur, E. The population genetics of commensal Escherichia coli. Nat. Rev. Microbiol. 2010, 8(3): 207-217. [CrossRef]
- Gordon, D.M. The ecology of Escherichia coli. In: Donnenberg, M.S. (ed.). Escherichia coli: Pathotypes and principles of pathogenesis. 2nd edition. London (UK): Academic Press. 2013, pp. 3-20.
- Frick, C., Vierheilig, J., Linke, R., Savio, D., Zornig, H et.al. Poikilothermic animals as a previously unrecognized source of fecal indicator bacteria in a backwater ecosystem of a large river. Appl. Environ. Microbiol. 2018, 84(16). [CrossRef]
- Suh, S., Moon, J. , Jung, S., Pyo, J. Improving Fecal Bacteria Estimation by Employing Machine Learning and Explainable Ai to Interpret the Relationship between Environmental Variables in Four Major Rivers, South Korea. 2024 SSRN.
- ISO 7704:1985, Water Quality-Evaluation of membrane filters used for microbiological analyses.
- ISO 9308-1/2014 Water quality — Enumeration of Escherichia coli and coliform bacteria—Part 1: Membrane filtration method for waters with low bacterial background flora.
- ISO 7899-2:2001. Water quality-Detection and enumeration of intestinal enterococci-Part2: Membrane filtration method.
- Mahleras A., Kontogianni A., Skourtos M. Title Report: Pinios river Basin -Greece, Subtitle report: Status report, EU, 2006.
- Oikonomou A. The Coastal Zone of the Penios River Delta: Development and Environmental Protection. Scientific edition II, Part 1-2 2005 pp.37-47.
- Filotis, Database for the Natural Environment of Greece 2015.
- Pineda J, Mösso C, Mestres M, Sierra JP, Sánchez-Arcilla A, González del Río J, Rodilla M. Análisis de la Bahía de Cullera. Implicaciones para una mejor gestión de los recursos costeros. VII Jornadas Españolas de Ingeniería de Costas y Puertos 2003, 210–211.
- Mestres M. 3D Simulation of pollutant dispersion in coastal waters. PhD thesis, Universitat Politècnica de Catalunya, 2002, pp. 376.
- Mestres M., Sánchez-Arcilla A, Sierra JP., Mösso C, et. al. Basis and tools for asustainable development of estuaries and coastal areas: Cullera Bay. Manage. Env. Quality 2004, 15: 25–32. [CrossRef]
|
Disclaimer/Publisher’s Note: The statements, opinions and data contained in all publications are solely those of the individual author(s) and contributor(s) and not of MDPI and/or the editor(s). MDPI and/or the editor(s) disclaim responsibility for any injury to people or property resulting from any ideas, methods, instructions or products referred to in the content. |
© 2024 by the authors. Licensee MDPI, Basel, Switzerland. This article is an open access article distributed under the terms and conditions of the Creative Commons Attribution (CC BY) license (http://creativecommons.org/licenses/by/4.0/).